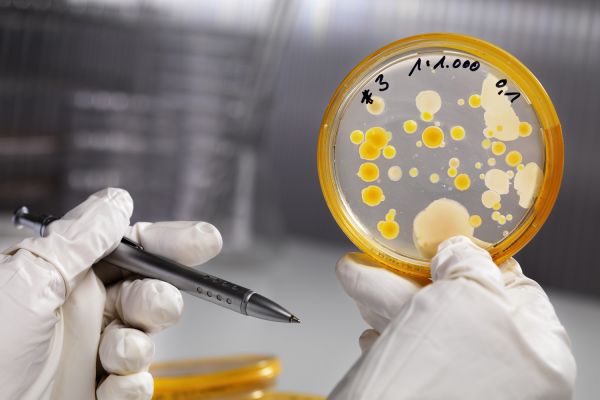

衣帽间的细菌 卓力帮你一并解决
发布时间:2018-09-06 16:24
所有衣服,由浅至深,从薄到厚,自上而下,都应该顺滑平整地有序排列着,这才是衣帽间应有的面貌。而现实是,洗完的衣服都皱皱的堆在一起。那么,让衣服恢复如初,通常是怎么处理的呢?

➤➤自然挂着
把皱的衣服用力甩甩,适当恢复后就直接挂上衣架,但是要想回到顺滑如初是完全不可能的。像衬衫的折痕,形成的时间越久后续就越难恢复。

➤➤熨烫平整
面对皱巴巴的衣服,我们要解决它,自然而然会想到熨烫。往往需要借助熨斗或是挂烫机的外力。可是,却忽视了重大问题: 水蒸汽渗透到衣服里面了。
衣帽间是相对封闭的环境,残留在衣服上的水汽会滋生细菌。有时还会产生难闻的异味,甚至导致衣服发霉。这个就是衣物的“二次污染”。
那正确的衣物除皱方法是什么呢?
➤➤干蒸汽熨烫
蒸汽”和“干”看似两种截然对立的元素,在CUORI卓力却成了最为默契的组合。卓力的聚能烫头具有二次加热的功能,可以将蒸汽再次进行汽化,形成高温高压干蒸汽,二次处理后的蒸汽不仅干燥,而且细腻,在瞬间除皱的同时,真正意义上做到即熨即干,即熨即穿。解决了蒸汽这一块,从源头上杜绝了细菌。
另一方面,喷射而出的98°高温强劲蒸汽,具有高效杀菌、除螨、祛异味的效果。而这要归功于卓力的创新蒸汽沁透增压技术。衣物受到细菌和螨虫的侵害时,很容易成为敏感肌肤的过敏源。卓力对衣物负责,更对你的每一寸肌肤负责。

熨烫给我们的穿衣带来了极大的便利,然而不完善的熨烫产品、错误的熨烫方式造成衣物的“二次污染”。如今,技术给我们提供了全新的可能--干蒸汽,它的存在,让我们娇贵的衣物始终远离细菌的侵害!

网址:衣帽间的细菌 卓力帮你一并解决 https://www.jiaju82.com/news-view-id-629365.html

